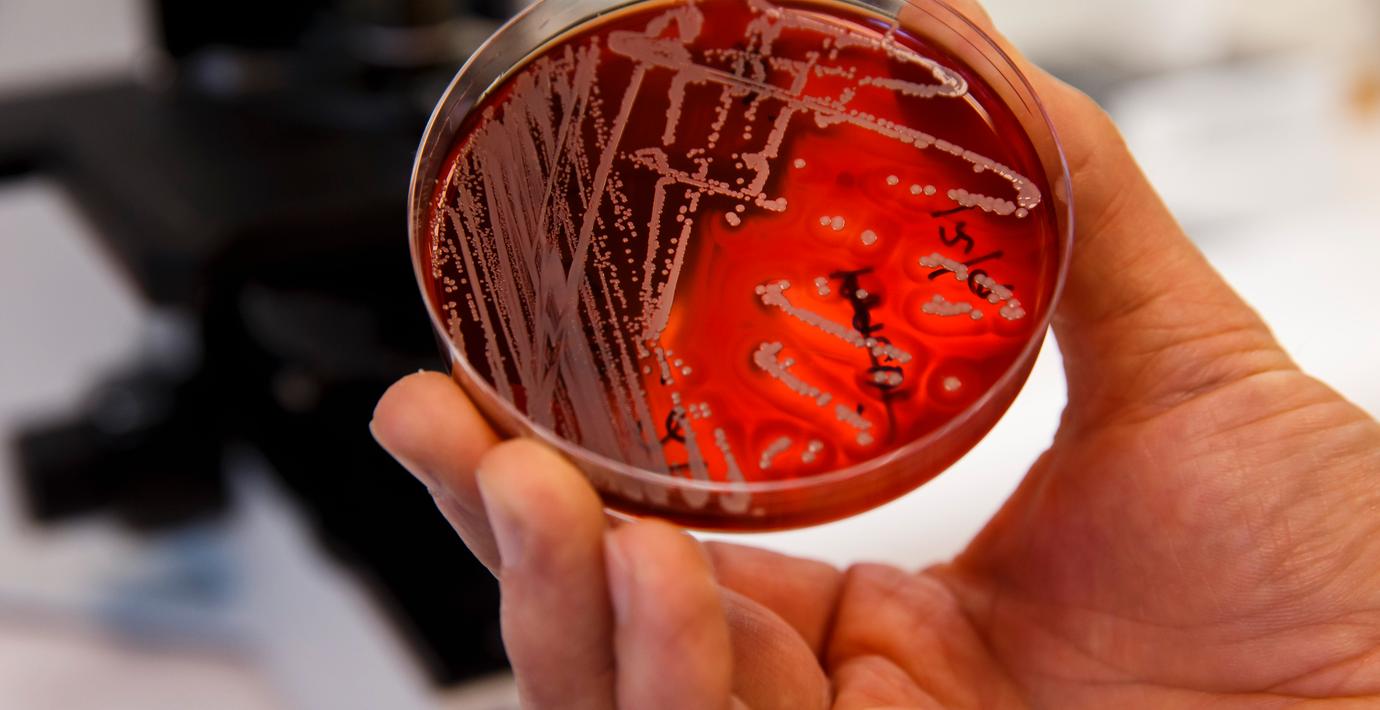

Studie: Äldre antibiotika var lika bra som nyare
Äldre typer av antibiotika är lika bra och i vissa fall bättre än nyare sorter. Det visar en ny svensk studie vid Folkhälsomyndigheten som publicerats i The Lancet Infectious diseases och som Ekot rapporterar om.
Personer som sökte vård på sjukhus för urinvägsinfektion fick lika bra effekt av ett äldre antibiotikapreparat jämfört med det nyare som används som standard. De fick också färre resistenta bakterier
– Lika många blev friska men man kunde se att det störde tarmfloran i betydligt mindre utsträckning, säger Charlotta Edlund som lett studien vid Folkhälsomyndigheten.
Omni är politiskt obundna och oberoende. Vi strävar efter att ge fler perspektiv på nyheterna. Har du frågor eller synpunkter kring vår rapportering? Kontakta redaktionen



